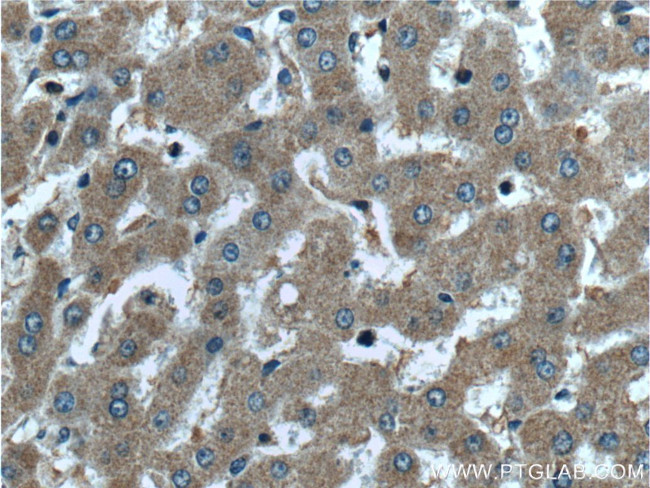
PROC Antibody in Immunohistochemistry (Paraffin) (IHC (P))

Search
Proteintech
PROC Polyclonal Antibody
{{$productOrderCtrl.translations['antibody.pdp.commerceCard.promotion.promotions']}}
{{$productOrderCtrl.translations['antibody.pdp.commerceCard.promotion.viewpromo']}}
{{$productOrderCtrl.translations['antibody.pdp.commerceCard.promotion.promocode']}}: {{promo.promoCode}} {{promo.promoTitle}} {{promo.promoDescription}}. {{$productOrderCtrl.translations['antibody.pdp.commerceCard.promotion.learnmore']}}
产品信息
25382-1-AP
种属反应
宿主/亚型
分类
类型
抗原
偶联物
形式
浓度
规格
纯化类型
保存液
内含物
保存条件
运输条件
产品详细信息
Immunogen sequence: DGIGSFSCD CRSGWEGRFC QREVSFLNCS LDNGGCTHYC LEEVGWRRCS CAPGYKLGDD LLQCHPAVKF PCGRPWKRME KKRSHLKRDT EDQEDQVDPR LIDGKMTRRG DSPWQVVLLD SKKKLACGAV LIHPSWVLTA AHCMDESKKL LVRLGEYDLR RWEKWELDLD IKEVFVHPNY SKSTTDNDIA LLHLAQPATL SQTIVPICLP DSGLAERELN QAGQETLVTG WGYHSSREKE AKRNRTFVLN FIKIPVVPHN ECSEVMSNMV SENMLCAGIL GDRQDACEGD SGGPMVASFH GTWFLVGLVS WGEGCGLLHN YGVYTKVSRY LDWIHGHIRD KEAPQKSWAP (113-461 aa encoded by BC034377)
靶标信息
Protein C is a vitamin K-dependent plasma glycoprotein that is cleaved to its activated form by the thrombin-thrombomodulin complex. Protein C in its activated form contains a serine protease domain and functions in degradation of the activated forms of coagulation factors V and VIII. Protein C is a vitamin K-dependent serine protease produced in the liver and made up of 2 polypeptide chains. The 62 kDa proenzyme is activated by thrombin bound to an endothelial surface receptor and the active enzyme cleaves factor Va and VIIIa and thus inhibits blood coagulation. The molecular weight of the active enzyme is 55 kDa and the normal concentrations in human plasma is approximately 1-3 ng/mL because of the very fast turnover, the proenzyme concentration is approximately 3 µg/mL. Mutations in the Protein C gene have been associated with thrombophilia due to protein C deficiency, neonatal purpura fulminans, and recurrent venous thrombosis.
仅用于科研。不用于诊断过程。未经明确授权不得转售。
篇参考文献 (0)
生物信息学
蛋白别名: activated protein C; Anticoagulant protein C; Autoprothrombin IIA; Blood coagulation factor XIV; coagulation factor XIV; EDQVDPRLIDGK; inactivator of coagulation factors Va, VIII; prepro-protein C; Protein C-Nagoya; type I protein C; unnamed protein product; Vitamin K-dependent protein C
基因别名: APC; PC; PROC; PROC1; THPH3; THPH4
UniProt ID: (Human) P04070, (Mouse) P33587
Entrez Gene ID: (Human) 5624, (Mouse) 19123